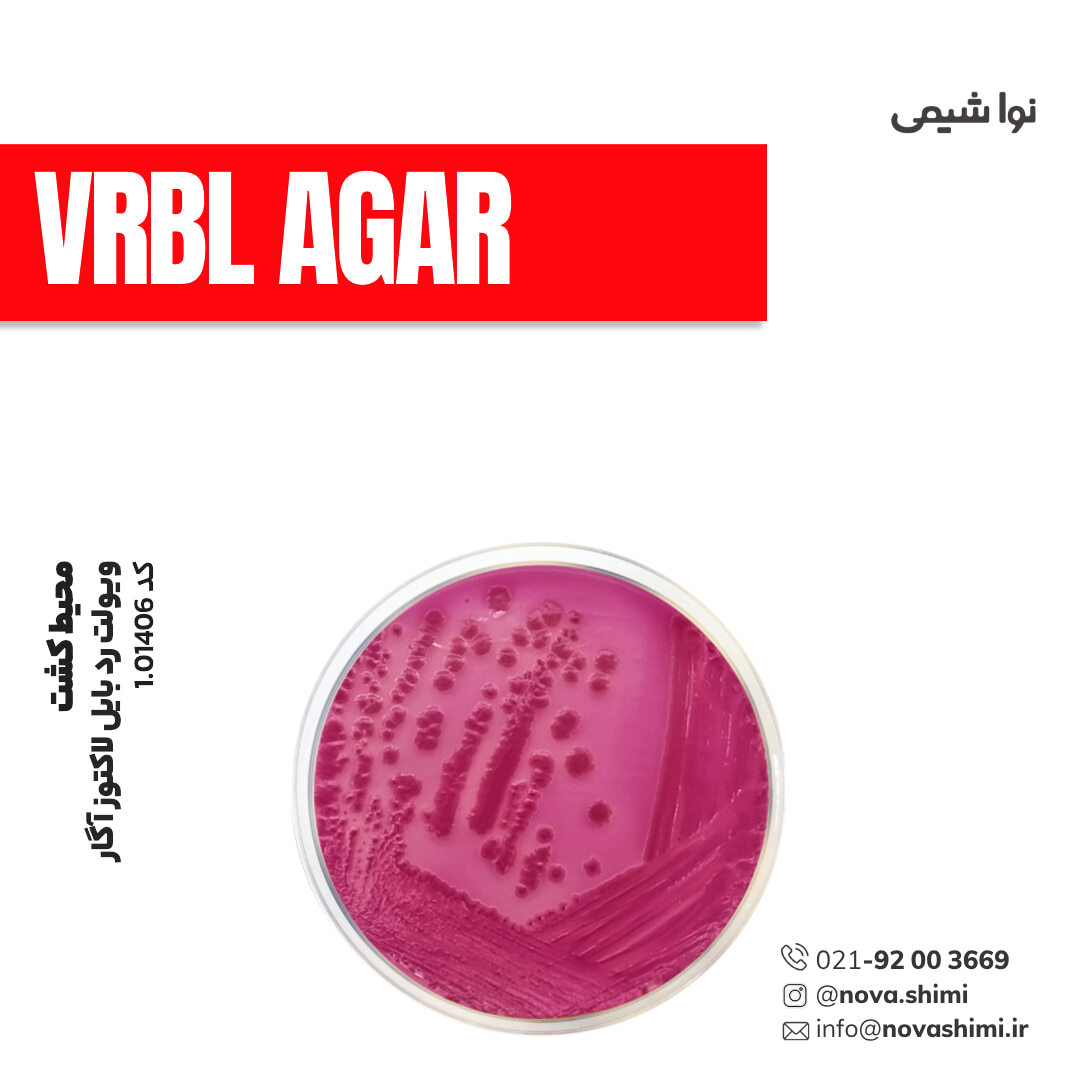
محیط کشت VRBL آگار مرک (Violet Red Bile Lactose agar)

محیط کشت VRBL آگار مرک (Violet Red Bile Lactose agar)
مشخصات فنی محیط کشت VRBL آگار:
1. برند: Merck Millipore
2. کاربرد: تشخیص و شمارش باکتریهای کولفرم مثبت
3. فرم فیزیکی: گرانول(granular)
4. حجم بسته: ۵۰۰ گرم و 5 کیلوگرم
محیط کشت VRBL آگار چیست؟
محیط کشت ویولت رد بایل لاکتوز آگار یک محیط انتخابی و افتراقی برای شمارش کلی فرمهای لاکتوز مثبت در غذا، آب و محصولات لبنی است. نُـواشیمی، به عنوان یکی از تامین کنندگان مواد آزمایشگاهی و محیط کشت برند مرک و سیگما آلدریچ، آماده ارائه خدمات فروش محیط کشت VRB agar مرک کد 1.01406 به شما عزیزان خواهد بود. برای دریافت اطلاعات فنی و استعلام قیمت محیط کشت ویولت رد بایل آگار مرک، از طریق شماره 02192003669 با کارشناسان فروش نُـوا شیمی تماس حاصل فرمایید.
برای آشنایی بیشتر با ویژگیها و مشخصات محصول، میتوانید با کلیک روی هر عنوان، به توضیحات تکمیلی در زیرعنوانهای مربوطه دسترسی پیدا کنید.
مشخصات محصول (Product Specifications)
مشخصات فنی محیط کشت VBRL agar مرک (Product Specifications)
در جدول زیر میتوانید مشخصات فنی محیط کشت ویولت رد بایل لاکتوز آگار مرک را مشاهده کنید.
عنوان | توضیحات |
|---|---|
نام محصول | Violet Red Bile Lactose Agar (VRBL Agar) |
کد محصول | 1.01406 |
برند | Millipore – Merck، سری GranuCult® prime |
استانداردها | ISO 4832, APHA, FDA-BAM |
فرم | گرانولار |
بستهبندی | 500 g ، 5 kg |
رنگ پودر | صورتی (pink) |
pH | 7.3–7.5 (پس از اتوکلاو، 40 g/L) |
حلالیت | 39.5 g/L |
چگالی ظاهری | 670 kg/m³ |
شرایط نگهداری | 15–25°C، محافظت از نور، درب کاملاً بسته |
استریل بودن | غیر استریل |
کاربرد | شناسایی و شمارش کلیفرمها |
Suitability | مناسب برای Coliforms |
Technique | میکروبیولوژی – کشت میکروبی |
Shelf life | تا ۵ سال (GranuCult® prime) |
برای مشاهده اطلاعات کامل محصول در سایت مرک و جزئیات کاربردی آن، بر روی VBRL agar کلیک کنید. شرکت نُـوا شیمی، تأمینکننده انواع محیط کشت برندهای معتبر مانند مرک و سیگما آلدریچ است و امکان خرید آسان و مطمئن این محصولات آزمایشگاهی را برای شما فراهم میکند.
خرید محیط کشت VRB agar مرک (GranuCult® Violet Red Bile Lactose agar)
خرید محیط کشت VRB agar مرک (GranuCult® prime Violet Red Bile Lactose agar) کد 1.01406
محیط کشت ویولت رد بایل لاکتوز آگار یا VRBL agar یک محیط انتخابی–افتراقی استاندارد برای شناسایی و شمارش کلنیهای کلیفرم لاکتوز مثبت در مواد غذایی، آب و خوراک دام است. حضور کریستال ویولت و نمکهای صفراوی باعث مهار رشد باکتریهای گرممثبت میشود، در حالی که تخمیر لاکتوز توسط کلیفرمها باعث تشکیل کلنیهای قرمز-بنفش همراه با هاله رسوب صفرا میگردد و امکان شناسایی دقیق و سریع را فراهم میکند.
کمپانی مِرک (MERCK)
شرکت مرک (Merck KGaA) یکی از قدیمیترین و معتبرترین کمپانیهای علمی و فناوری در جهان است که در سال 1668 در آلمان تأسیس شد و امروزه بهعنوان پیشگام جهانی در حوزههای مواد شیمیایی آزمایشگاهی، بیوتکنولوژی و داروسازی شناخته میشود. بخش مواد آزمایشگاهی مرک، طیف گستردهای از مواد شیمیایی با گریدهای مختلف از جمله آنالیتیکال، ACS، HPLC، و Suprapur® را ارائه میدهد که برای تحقیقات علمی، کنترل کیفیت صنعتی، و مصارف آموزشی کاربرد دارند.
شرکت نُـوا شیمی، تامین کننده مواد آزمایشگاهی محیط کشت
شرکت نُـوا شیمی، با سابقهای درخشان در تامین مواد آزمایشگاهی، استاندارد ها و تجهیزات آزمایشگاه، با دسترسی گسترده به محصولات برندهای معتبر داخلی و بینالمللی، تامین نیازهای صنایع، آزمایشگاههای تحقیقاتی و داروسازی را با رویکردی مدرن و دقیق دنبال میکند. در صورت نیاز به استعلام قیمت محیط کشت ویولت رد بایل لاکتوز آگار مرک کد 1.01406 یا سایر مواد آزمایشگاهی، استاندارد و رفرنسهای آزمایشگاهی کارشناسان ما از طریق خط ویژه 02192003669 آماده پاسخگویی و ارائه مشاوره تخصصی به شما خواهند بود.
آنالیز و کیفیت (Analysis Note)
ویژگیهای آنالیزی و کیفیت (Analysis Note)
Appearance (ظاهر): قرمز، شفاف پس از آمادهسازی
pH (25°C): بین 7.2 تا 7.6
Color of colonies: کلنیهای قرمز-بنفش با یا بدون هاله رسوب
Inhibition: مهار کامل Enterococcus spp.
Growth Promotion: بهبود رشد ≥ 50٪ برای سویههای استاندارد مطابق DIN EN ISO 11133
Solidification: مایع در 45°C — مناسب برای پورپلیت
Selectivity: انتخابی برای کلیفرمها؛ مهارگر گرممثبتها با کریستال ویولت و نمک صفرا
Indicator: نیوترال رد (Neutral Red) برای نمایش تخمیر لاکتوز
جدول راهنمای ویژگیهای آنالیزی محیط کشت GranuCult® prime VBRL agar
ویژگی | توضیحات | تحلیل و اهمیت |
|---|---|---|
Appearance (ظاهر فیزیکی) | گرانول یکنواخت، سبز زیتونی | سهولت در پیمانهگیری و کاهش گرد و غبار |
Color (رنگ) | سبز | وجود Brilliant Green بهعنوان عامل مهارکننده |
pH (30°C, 40 g/L, after autoclaving) | 7.2 | pH ایدهآل برای رشد انتخابی کلیفرمها و E. coli |
Form (فرم فیزیکی) | محیط کشت گرانولار GranuCult® prime | انحلال بهتر، پایداری بیشتر، حداقل کلوخه |
Solubility (حلالیت) | 40 g/L | نشاندهنده کیفیت بالا و انحلال یکنواخت |
Bulk Density | 560 kg/m³ | برای تنظیم دقیق وزن و حجم در آزمایشگاه |
Growth Promotion Test | بازیابی مطلوب کلیفرم و E. coli مطابق استانداردها | تضمین کارایی محیط در تستهای کنترل کیفیت |
Selectivity (انتخابپذیری) | مهارکننده رشد Gram-positive؛ انتخابی برای کلیفرمهای گرم-منفی | اختصاصیسازی آزمون و کاهش نتایج مثبت کاذب |
Colony / Gas Characteristics | تخمیر لاکتوز + تولید گاز در لوله Durham | شاخص سریع برای شناسایی Coliform و E. coli |
Application (کاربرد) | تأیید نتایج MPN، شمارش و غنیسازی Coliform/E. coli | استاندارد در صنایع غذایی، آب و خوراک دام |
Packaging (بستهبندی) | 500 g، 5 kg | مناسب برای مصرفکنندگان صنعتی و آزمایشگاهی |
Storage Condition (شرایط نگهداری) | خشک، دور از رطوبت، ظرف دربسته | جلوگیری از افت کیفیت و جذب رطوبت |
کاربردهای محیط کشت VBRL agar
مهمترین کاربردهای محیط کشت VBRL agar:
در ادامه، کاربردهای محیط کشت VBRL agar مرک را مطالعه خواهیم نمود:
1. شمارش انتخابی کلیفرمها در نمونههای غذایی
VRBL محیط مرجع استاندارد برای Enumeration of Coliforms طبق ISO 4832 است و بهطور گسترده در صنایع غذایی، لبنیات، گوشت، نوشیدنی و کنسروها بهکار میرود.
2. تشخیص و شمارش E. coli بهصورت غیرمستقیم
کلنیهای تخمیرکننده لاکتوز (قرمز با هاله رسوب) معمولا نشاندهنده حضور E. coli و سایر کلیفرمهای فیکل هستند.
3. پایش میکروبی آب و پساب
در آزمایشگاههای محیطزیست برای monitoring of fecal contamination در آب آشامیدنی، آب استخرها، چاهها و effluent استفاده میشود.
4. کنترل کیفیت میکروبی در صنایع لبنی
VRBL یکی از اصلیترین محیطهای Quality Control برای شیر خام، شیر پاستوریزه، پنیر، خامه و دوغ است.
5. آزمونهای میکروبیولوژی در صنایع دارویی
برای بررسی احتمال آلودگیهای فیکال و رشد کلیفرمها در مواد اولیه، مواد بستهبندی و محصول نهایی بهکار میرود.
6. شناسایی سریع کلنیهای تخمیرکننده لاکتوز
وجود bile salts و crystal violet باعث مهار باکتریهای گرم مثبت شده و امکان مشاهدهی مستقیم کلنیهای شاخص (قرمز با رسوب) را فراهم میکند.
7. کنترل بهداشتی خطوط تولید و تجهیزات
در پایش سطوح، خطوط بستهبندی و CIP برای تشخیص آلودگیهای احتمالی ناشی از کلیفرمها استفاده میشود.
8. تستهای تحقیقاتی و آکادمیک
مناسب برای مطالعات مرتبط با Enterobacteriaceae, متابولیسم لاکتوز، و خصوصیات تخمیری باکتریهای گرم منفی رودهای.
برای دریافت استعلام قیمت محیط کشت VBRL agar مرک کد 1.01406، لطفا با شماره 02192003669 تماس حاصل فرمایید. کارشناسان ما آماده پاسخگویی به سوالات شما هستند.
نکات ایمنی
نکات ایمنی و نگهداری (Safety & Storage)
در ادامه نکات ایمنی استفاده از محیط کشت ویولت رد بایل لاکتوز آگار مرک (GranuCult® prime VBRL agar) برند مرک را مطالعه خواهیم نمود:
ویژگی ایمنی | توضیحات | تحلیل و اهمیت |
|---|---|---|
Hazard Classification (طبقهبندی خطر) | Aquatic Chronic 3 | نشاندهنده اثرات زیستمحیطی طولانیمدت؛ دفع اصولی ضروری است. |
Hazard Statement (جملات خطر) | H412: مضر برای موجودات آبزی با اثرات طولانیمدت | جلوگیری از ورود به محیطزیست اهمیت دارد. |
Precautionary Statements (دستورالعملهای احتیاطی) | P273: از رهاسازی در محیطزیست خودداری شود | جلوگیری از آلودگی آبها و خاک. |
| P501: ضایعات را مطابق قوانین محلی دور بریزید | دفع صحیح برای جلوگیری از خطرات زیستمحیطی. |
Personal Protective Equipment (تجهیزات حفاظت فردی) | دستکش، عینک آزمایشگاهی، روپوش | جلوگیری از تماس پوستی و چشمی. |
Handling (نحوه کار با ماده) | از ایجاد گرد و غبار جلوگیری شود | استنشاق ذرات میتواند باعث تحریک شود. |
Storage Class Code (کد نگهداری) | 11 – Combustible Solids | دور از منابع حرارت و جرقه نگهداری شود. |
WGK (طبقهبندی خطر برای آب) | WGK 3 – بسیار خطرناک برای محیطزیست | نشاندهنده نیاز به مراقبت ویژه در هنگام دفع. |
First Aid (کمکهای اولیه) | تماس چشمی: شستشو با آب فراوان / استنشاق: انتقال به هوای تازه | کاهش سریع اثرات تحریککننده. |
Environmental Protection (محافظت زیستمحیطی) | جلوگیری از ورود به شبکه فاضلاب | به دلیل خطر بالا برای منابع آب. |
اگر به دنبال محیط کشت VBRL agar مرک هستید، نُـوا شیمی همراهی مطمئن در مسیر تامین نیاز های شما خواهد بود. برای سفارش، دریافت مشاوره فنی و آگاهی از شرایط همکاری؛ از طریق شماره 02192003669 با تیم فروش در ارتباط باشید.
سوالات متداول (FAQ)
سوالات متداول درباره محیط کشت VRBL آگار:
1. VRBL Agar برای شناسایی چه میکروارگانیسمهایی استفاده میشود؟
این محیط برای شمارش و جداسازی انتخابی کلیفرمها (Coliforms) بهویژه گونههای E. coli در مواد غذایی، آب و نمونههای محیطی استفاده میشود.
2. چرا در VRBL از بایل سالت و کریستال ویوله استفاده میشود؟
این ترکیبات رشد باکتریهای گرممثبت را مهار کرده و محیط را برای رشد انتخابی کلیفرمهای گرممنفی فراهم میکنند.
3. کلنیهای مثبت (کلیفرمها) روی VRBL چه ویژگی دارند؟
کلیفرمها معمولا قرمز تا صورتی با هاله رسوبکننده (precipitation zone) دیده میشوند؛ به دلیل تخمیر لاکتوز و تولید اسید.
4. این محیط طبق کدام استانداردها استفاده میشود؟
VRBL Agar مطابق استانداردهای ISO 4832، APHA، FDA-BAM برای شمارش میکروبی استفاده میشود.
5. شرایط نگهداری VRBL Agar چیست؟
در محیط خشک، خنک، به دور از رطوبت و در دمای 15 تا 25 درجه سانتیگراد نگهداری شود.
6. آیا VRBL Agar برای شمارش مستقیم استفاده میشود یا نیاز به پیشغنیسازی دارد؟
برای بسیاری از نمونههای غذایی طبق ISO 4832 بهصورت مستقیم (Pour Plate) استفاده میشود؛ اما برای نمونههای کمبار میکروبی ممکن است پیشغنیسازی لازم باشد.
7. آیا VRBL Agar انتخابی کامل است؟
خیر، نسبتا انتخابی است؛ یعنی عمدتاً کلیفرمها را رشد میدهد اما برخی گرممنفیهای دیگر نیز ممکن است رشد کنند.
8. رنگ کلنیهای E. coli روی VRBL چگونه است؟
اغلب قرمز تیره با هاله رسوب صفرا که از لاکتوز تخمیر شده ناشی میشود.

هنوز نظری ثبت نشده
اولین نفری باشید که نظر میدهید
ثبت نظر